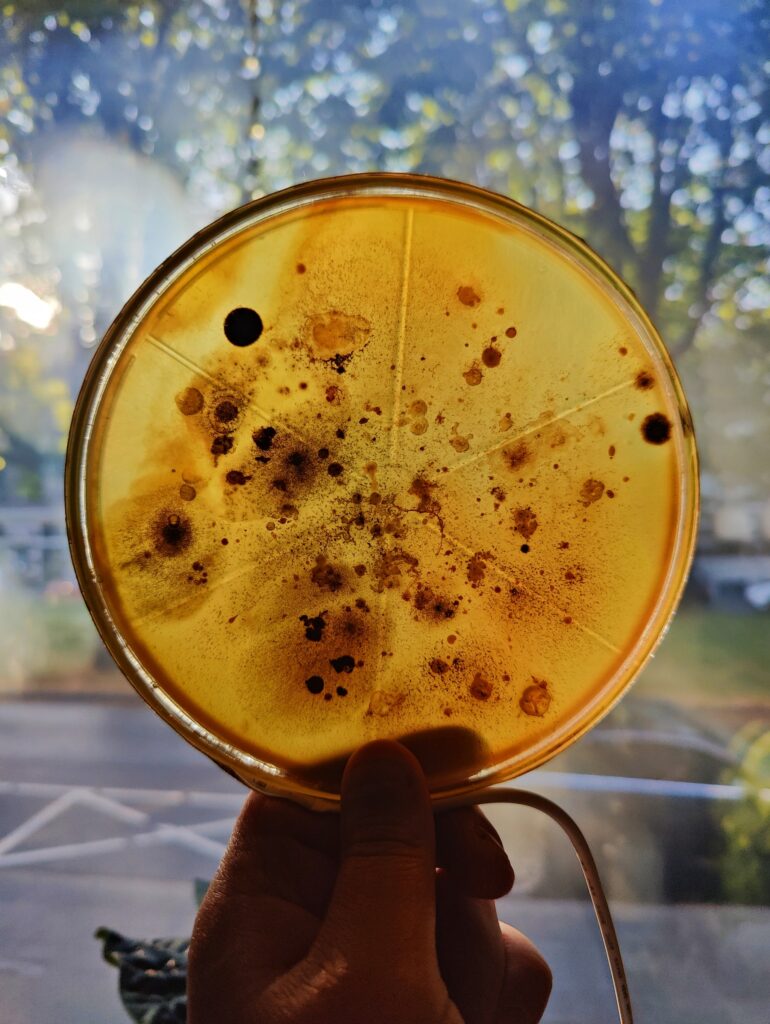
Biolumina Microbial lampscapes by Lianne Regtuit round petri dishes through natural light Biolumina Microbial lampscapes by Lianne Regtuit round petri dishes through natural light

Biolumina
Microbial lampscapes
by Lianne Regtuit
Light design
Biolumina: Microbial Lampscapes presents an innovative fusion of art and science, featuring table lamps adorned with home-grown bacteria and fungi. Cultivated on a self developed agar nutrient medium, these captivating microbial communities are encapsulated and preserved within epoxy resin cubes and disks, emitting a enchanting glow.
The intention behind Biolumina is to challenge preconceived notions of bacteria and fungi, often perceived as unsightly or even harmful. In reality, these microorganisms play a crucial role in sustaining life on Earth. Without them, our existence would be impossible.
Through this artwork, I aim to shift perspectives and foster appreciation for the inherent beauty and importance of bacteria and fungi. Just like the awe-inspiring wonders of nature, they deserve to be celebrated and admired. These lamps stand for where science meets art to illuminate the beauty of the microscopic realm.
Lianne Regtuit
Biobased Art & Design
Contact
Do not hesitate to contact me to discuss a possible project or learn more about my work.
© 2025 Lianne Regtuit